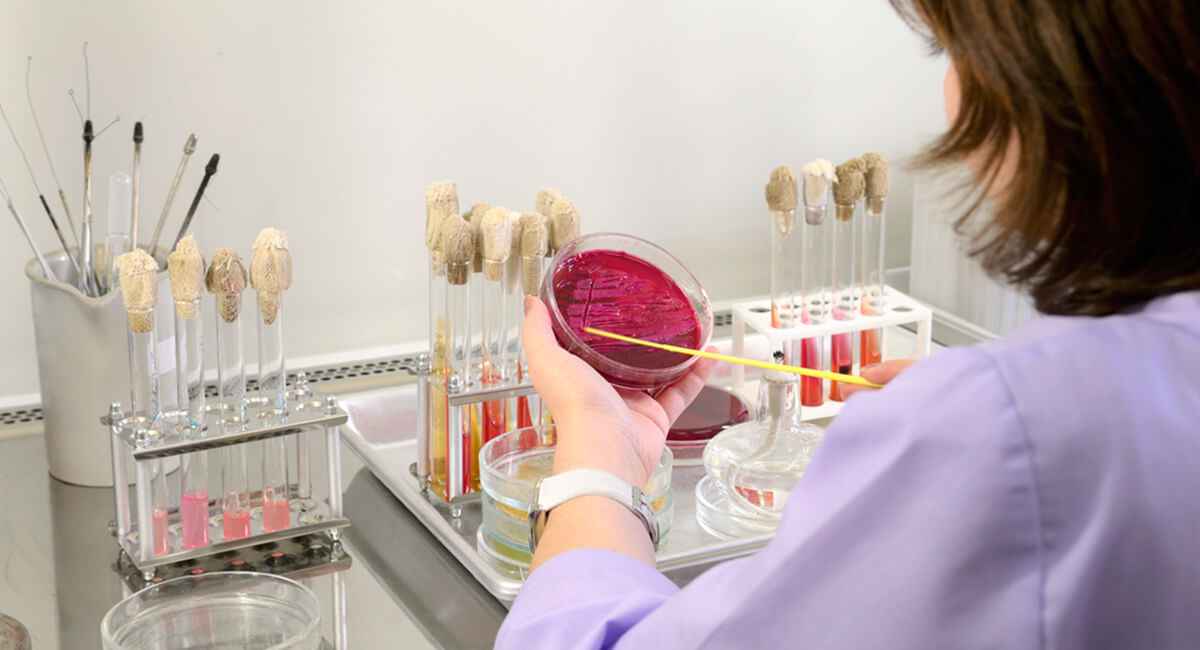
Actualización en la interpretación y recogida de muestras en enfermedades infecciosas

Descripción — Actualización en la interpretación y recogida de muestras en enfermedades infecciosas
Temario del Actualización en la interpretación y recogida de muestras en enfermedades infecciosas
1 Actualización en la interpretación y recogida de muestras en enfermedades infecciosas
- Tema I. Introducción y Objetivos. Normas básicas generales en la recogida de muestras.
- Tema II. Interpretación y de recogida de muestras en Hemocultivo.
- Tema III. Interpretación y de recogida de muestras en Urocultivo.
- Tema IV. Interpretación y de recogida de muestras en Tracto Gastrointestinal.
- Tema V. Interpretación y de recogida de muestras en Tracto Respiratorio.
Ediciones
| Fecha inicio | Fecha fin | |
| 1 | 28/01/2022 | 24/03/2022 |
| 2 | 28/03/2022 | 24/05/2022 |
Acreditación por — CFC Comisión de formación continuada
Plazas agotadas
Lo sentimos, actualmente no hay plazas disponibles para este curso.
Avisar cuando haya plazas